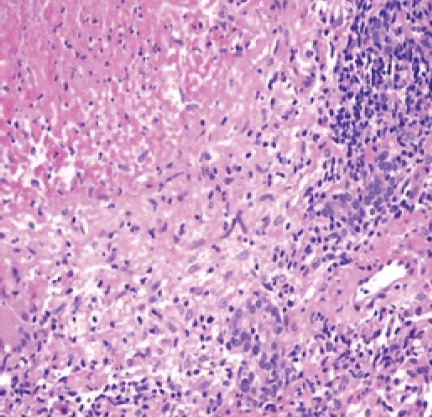

This article emphasizes the importance of early recognition and prompt treatment of tuberculous dactylitis (bilateral spina ventosa) in children to prevent long-term disability. It highlights the rarity of bilateral involvement and underscores the need for comprehensive diagnostic evaluation, structured rehabilitation, and discussion on public health implications.
Dr. Rahul Gupta, Department of Orthopaedic Surgery, Lala Lajpat Rai Memorial Medical College, Meerut - 250004, Uttar Pradesh, India. E-mail: rahulgupt007@gmail.com
Abstract
Introduction: Tuberculous (TB) dactylitis (spina ventosa) is a rare form of extrapulmonary tuberculosis involving the short tubular bones of the hands and feet, primarily in children. Due to its non-specific presentation, the diagnosis is often delayed.
Case Report: We report a rare case of bilateral spina ventosa in a 6-year-old girl who presented with progressive painful swelling of both middle and ring fingers. Diagnosis was confirmed by cartridge-based nucleic acid amplification test, erythrocyte sedimentation rate elevation, positive Mantoux test, and histopathology revealing epithelioid granulomas with Langhans giant cells. The patient received anti-tubercular therapy – isoniazid (10 mg/kg/day), rifampicin (15 mg/kg/day), pyrazinamide (35 mg/kg/day), and ethambutol (20 mg/kg/day) – for 12 months, showing excellent functional and radiological recovery.
Conclusion: Early diagnosis and timely management of TB dactylitis are crucial to prevent deformity and disability. Clinicians should maintain a high index of suspicion in endemic areas when evaluating chronic finger swellings.
Keywords: Tuberculous dactylitis, spina ventosa, pediatric tuberculosis, curettage, rehabilitation.
Tuberculous (TB) dactylitis is a form of extrapulmonary tuberculosis affecting the metacarpals, metatarsals, and phalanges, and typically occurs in young children. The hand is more frequently involved than the foot [1], and the disease is radiologically recognized as “spina ventosa” due to cystic bone expansion caused by granulomatous inflammation [2].
A 6-year-old girl presented to the outpatient department with complaints of painful swelling in the middle finger of the right hand and ring finger of the left hand for the past 8 months (Fig. 1). The swelling was gradually progressive and was associated with mild fever, loss of appetite, and weight loss. There was no history of trauma, tuberculosis contact, or previous anti-tubercular therapy (ATT) intake.

Figure 1: Clinical photographs of the patient.
On examination, both affected fingers showed spindle-shaped swellings that were firm in consistency and tender to touch, with restricted motion at the proximal interphalangeal joints.
Laboratory investigations
Hemoglobin was 12.2 g/dL, total leukocyte count was 7480/cm (51% neutrophils, 42% lymphocytes), and erythrocyte sedimentation rate was 25 mm/h. Mantoux test showed 14 mm induration at 48 h. Human immunodeficiency virus, venereal diseases research laboratory, and blood culture were negative.
Radiological findings
X-rays revealed cystic expansion and cortical thinning [3] of the proximal phalanges with lytic lesions (Fig. 2). Computed tomography imaging confirmed cortical destruction and periosteal reaction (Fig. 3).

Figure 2: X-ray B/L hands showing involvement of phalanx.

Figure 3: Computed tomography radiographs.
Pathological findings
The cartridge-based nucleic acid amplification test (CBNAAT) was positive for Mycobacterium tuberculosis. Ziehl–Neelsen stain demonstrated acid-fast bacilli. Histopathology showed epithelioid granulomas with Langhans giant cells (Fig. 4) and caseous necrosis, diagnostic of TB osteomyelitis.
Figure 4: Tuberculous granuloma with central necrosis, epitheloid cells.
Treatment
ATT was initiated with isoniazid (10 mg/kg/day), rifampicin (15 mg/kg/day), pyrazinamide (35 mg/kg/day), and ethambutol (20 mg/kg/day) for 2 months (intensive phase), followed by isoniazid and rifampicin for 10 months (continuation phase). Surgical debridement and curettage were performed to remove necrotic tissue. Gentle physiotherapy and finger mobilization were started after 3 weeks of therapy [2].
Follow-up
At 3 months, radiographs demonstrated complete good healing with cortical restoration (Fig. 5). The patient achieved a full range of motion without deformity. A structured rehabilitation program, including active and passive exercises and grip strengthening, ensured complete functional recovery.

Figure 5: Follow-up radiographs of the patient on anti-tubercular therapy for 3 months.
Skeletal tuberculosis occurs in 1.5% children who have untreated initial pulmonary tuberculosis [1]. Bone and joint tuberculosis occurs in the spine (51%), pelvis (12%), hip and femur (10%), knee and tibia (10%), ribs (7%), and involvement of small bones of the hand and feet is rare [4]. It spreads hematogenously from a primary focus, often pulmonary, though pulmonary involvement may not always be present. Only 1/3rd of the patients with skeletal tuberculosis are diagnosed with concomitant active pulmonary tuberculosis [5]. Pulmonary tubercular involvement is not common in the case of Tuberculous dactylitis [2].
With occlusion of the nutrient artery of the involved bone and the destruction of internal lamella (or formation of sequestra), there is endosteal destruction and concomitant subperiosteal new bone formation; successive layers of subperiosteal new bone formation are deposited over the involved bone [6].
The first inoculum of the infection is lodged in the center of the marrow cavity, and the interior of the short tubular bone is converted virtually into a TB granuloma. This leads to a spindle-shaped expansion of the bone (spina ventosa), and sclerosis may occur in long-standing cases [7]. Radiologically, in the spina ventosa, the bone may take the shape of honeycomb, diffuse uniform infiltration, or a cystic lesion. Or rarely, the involved bone may show atrophy. Fieilchenfeld in 1896 described TB dactylitis roentgen-graphically in children [8].
Bilateral involvement, as in our case, is exceptionally uncommon. Previous studies (Agarwal et al., Ali et al.) predominantly reported unilateral cases. The main differentials include pyogenic osteomyelitis, neoplasms, and sickle-cell dactylitis. However, the presence of Langhans giant cells and positive CBNAAT confirmed the diagnosis.
Management is essentially by anti-tubercular drugs [5,9], with rest to the part in a functioning position and early active exercises of the involved parts or joints. Early diagnosis offers the chance to preserve normal hand function since M. tuberculosis does not develop the proteolytic enzymes that might damage cartilage [10].
Early recognition and prompt ATT are vital for preventing bone destruction and deformity. Surgical intervention is reserved for debridement or curettage in cystic lesions, whereas physiotherapy maintains joint mobility. If a finger has ankylosed at more than one joint, or is grossly deformed, scarred, and interfering with normal hand functioning, amputation of the finger or the corresponding ray may be advised [1].
TB dactylitis (spina ventosa) of the proximal phalanx is an uncommon but significant manifestation of extrapulmonary tuberculosis in children. Awareness among clinicians is essential for early diagnosis and appropriate management to prevent functional impairment. A combination of medical therapy and timely rehabilitation ensures optimal recovery.
Public health implications
Tuberculosis remains endemic in several regions, and extrapulmonary manifestations such as TB dactylitis in children are often underdiagnosed. Early clinical suspicion, use of molecular diagnostic tools, and timely therapy can prevent long-term disability. This case highlights the need for increased awareness and early screening in pediatric populations, especially in endemic areas.
TB dactylitis should be considered in children presenting with chronic finger swelling, especially in endemic regions. Early suspicion, confirmatory diagnosis using CBNAAT and histopathology, and complete ATT lead to excellent outcomes. Prompt initiation of physiotherapy prevents stiffness and deformity, preserving full hand function. The extremely rare occurrence of this disease bilaterally makes this case noteworthy and highlights the importance of reporting such cases in the future.
References
- 1. Tuli SM. Tuberculosis of the Skeletal System (Bones, Joints, Spine and Bursal Sheaths). 4th ed. New Delhi: Jaypee Brothers Medical Publishers (P) Ltd.; 2010. [Google Scholar] [PubMed]
- 2. American Thoracic Society, Center for Disease Control and Prevention, Infectious Diseases Society of America. Treatment of tuberculosis. MMWR Recomm Rep 2003;52:1-77. [Google Scholar] [PubMed]
- 3. Sante LR. Principles of Roentgenologic Interpretation. 11th ed. Ann Arbor, MI: Edwards Bros; 1958. p. 109. [Google Scholar] [PubMed]
- 4. Panchonia A, Kulkarni CV, Mehar R, Mandwariya S. Isolated tuberculous dactylitis (spina ventosa) in a 9 year old boy – a rare entity. Int J Basic Appl Med Sci 2012;2:52-5. [Google Scholar] [PubMed]
- 5. Daniel TM, DebaBanne SM. The serodiagnosis of tuberculosis and other mycobacterial diseases by enzyme-linked immunosorbent assay. Am Rev Respir Dis 1987;135:1137-51. [Google Scholar] [PubMed]
- 6. Andronikou S, Smith B. “Spina ventosa”–tuberculous dactylitis. Arch Dis Child 2002;86:206. [Google Scholar] [PubMed]
- 7. Agarwal S, Caplivski D, Bottone EJ. Disseminated tuberculosis presenting with finger swelling in a patient with tuberculous osteomyelitis: A case report. Ann Clin Microbiol Antimicrob 2005;3:18. [Google Scholar] [PubMed]
- 8. Pearlman HS, Warren RF. Tuberculous dactylitis. AM J Surg 1961;101:769-71. [Google Scholar] [PubMed]
- 9. Ali N, Bhat A, Fatima A, Muzzafar K, Latoo IA, Singh R. Tuberculous dactylitis: A case series and review of literature. J Pioneer Med Sci 2014;4:184-90. [Google Scholar] [PubMed]
- 10. Nelson LJ, Wells CD. Global epidemiology of childhood tuberculosis. Int J Tuberc Lung Dis 2004;8:636-47. [Google Scholar] [PubMed]








